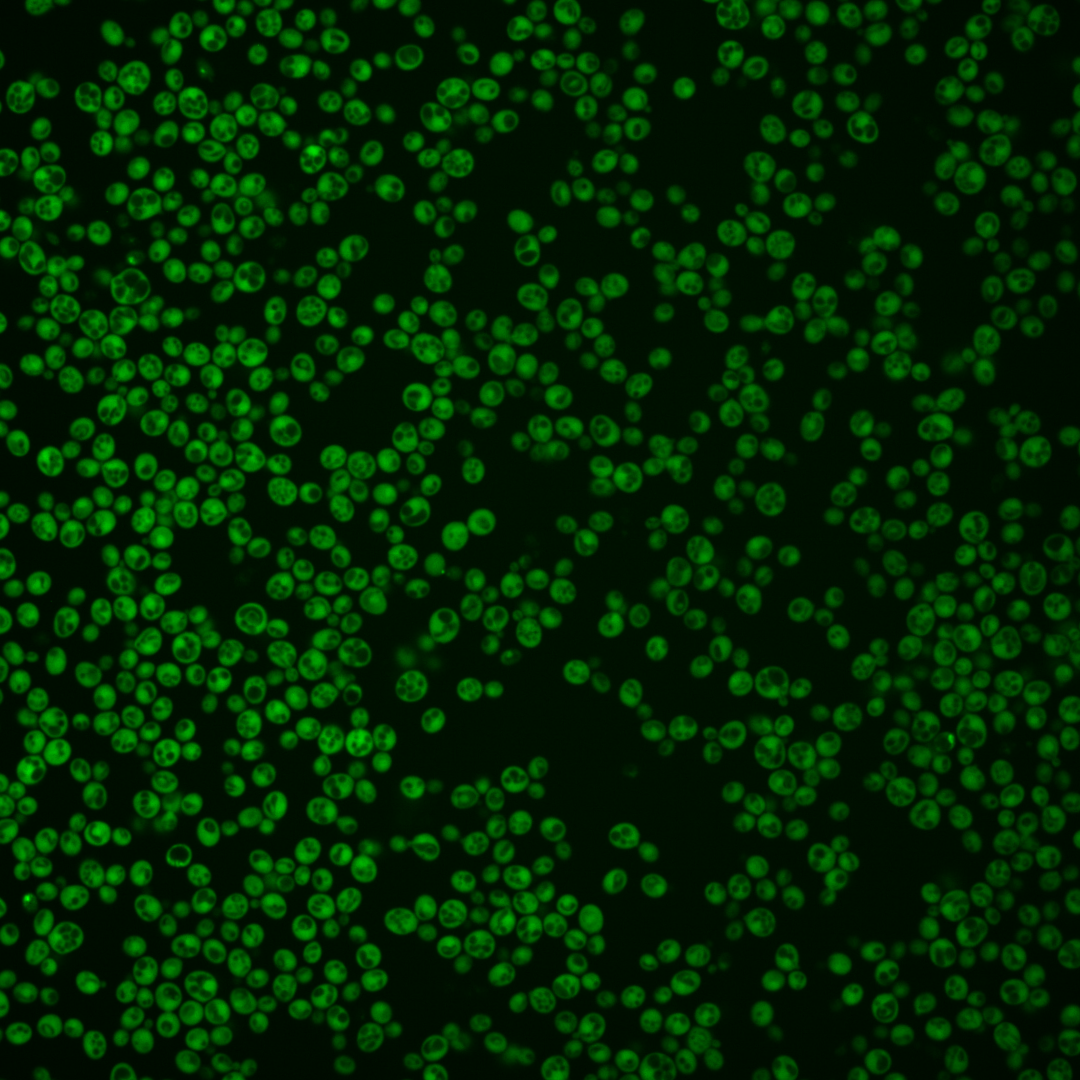
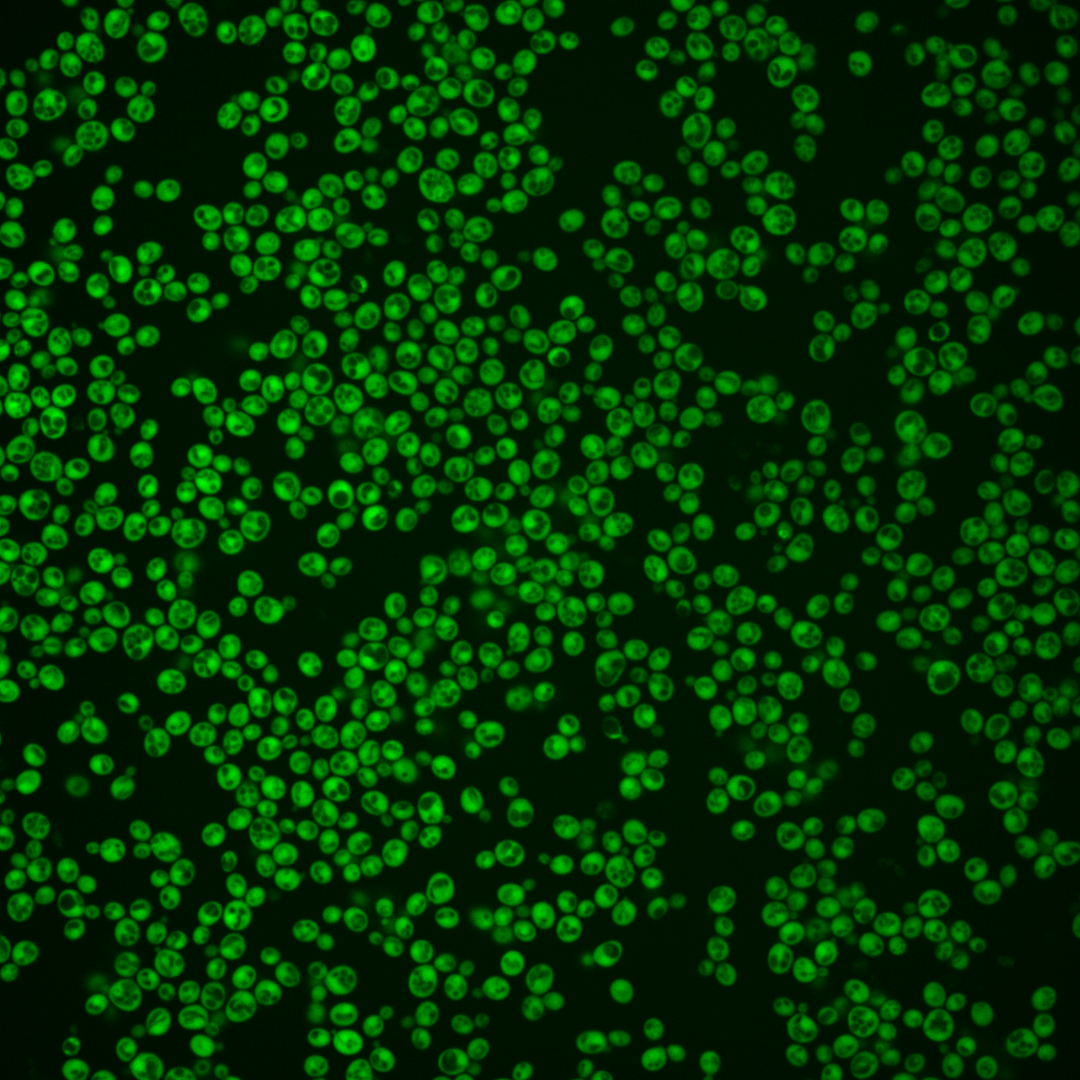
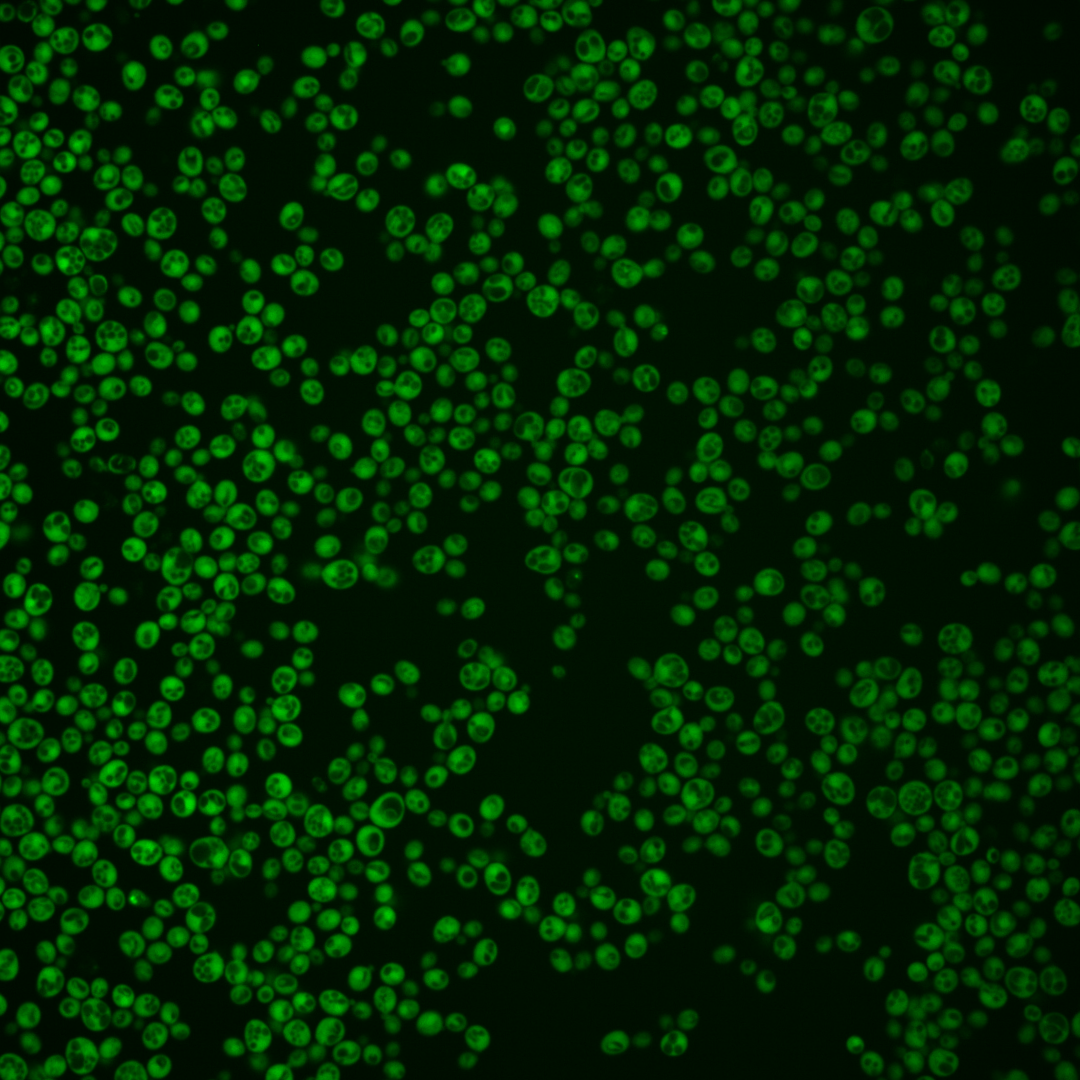
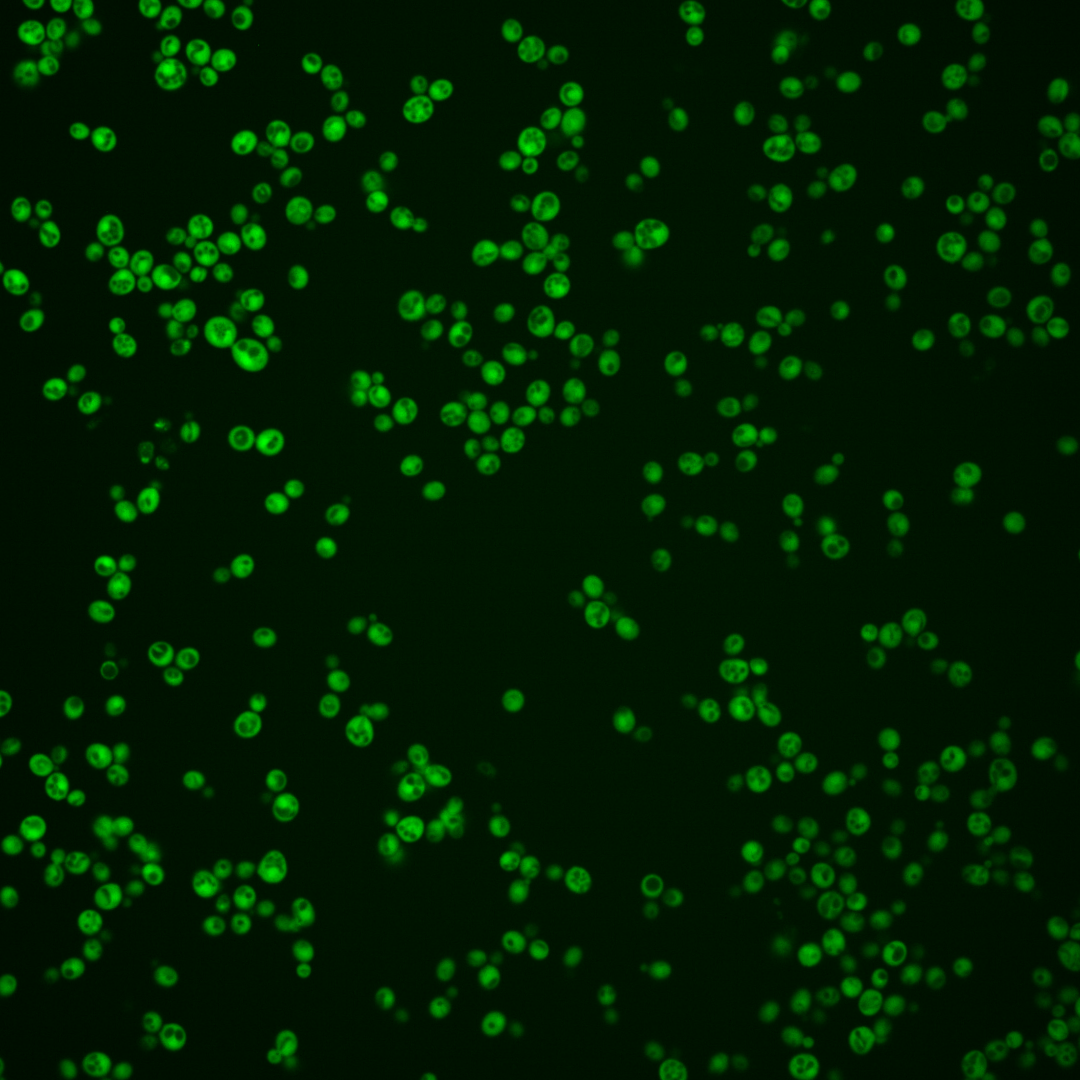
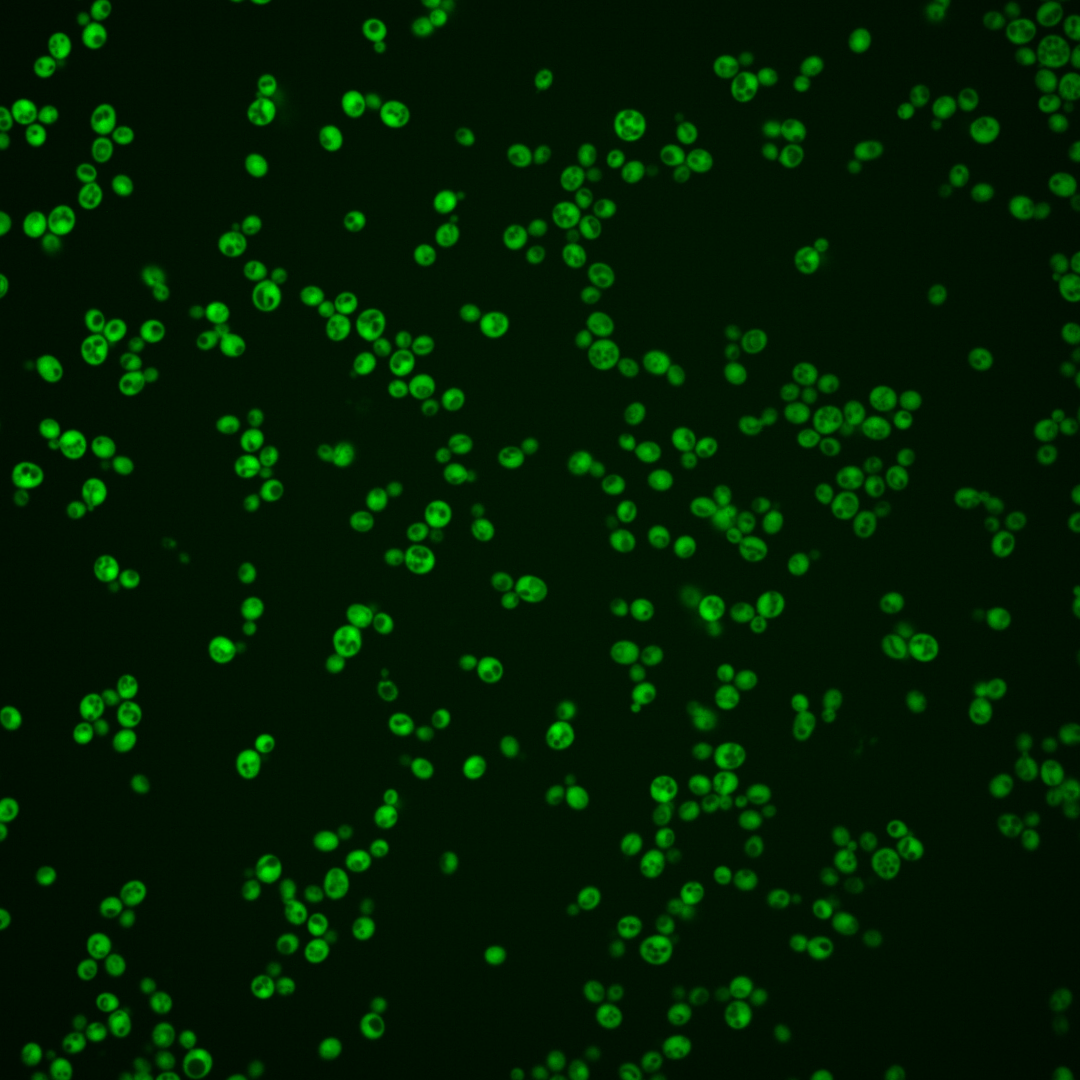
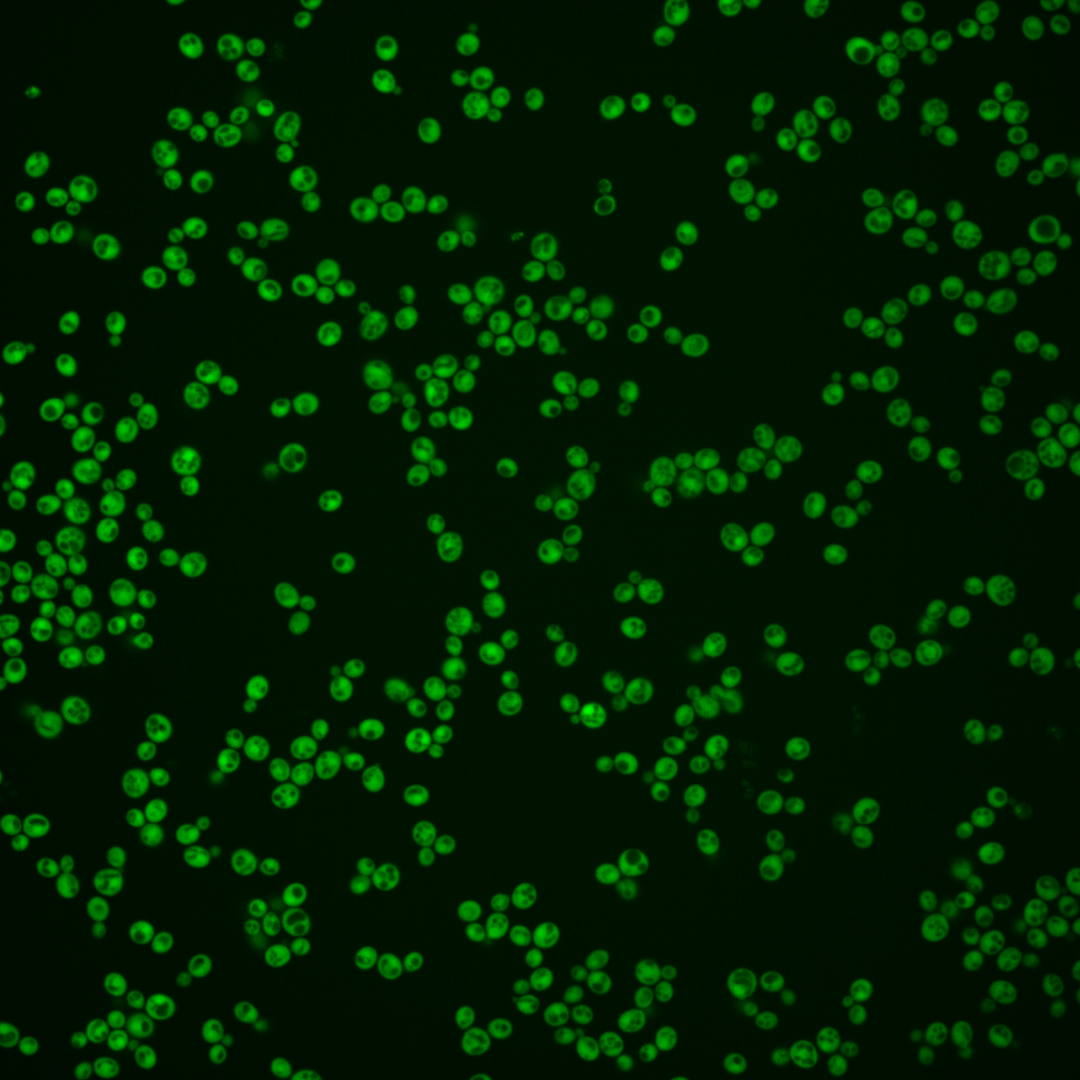
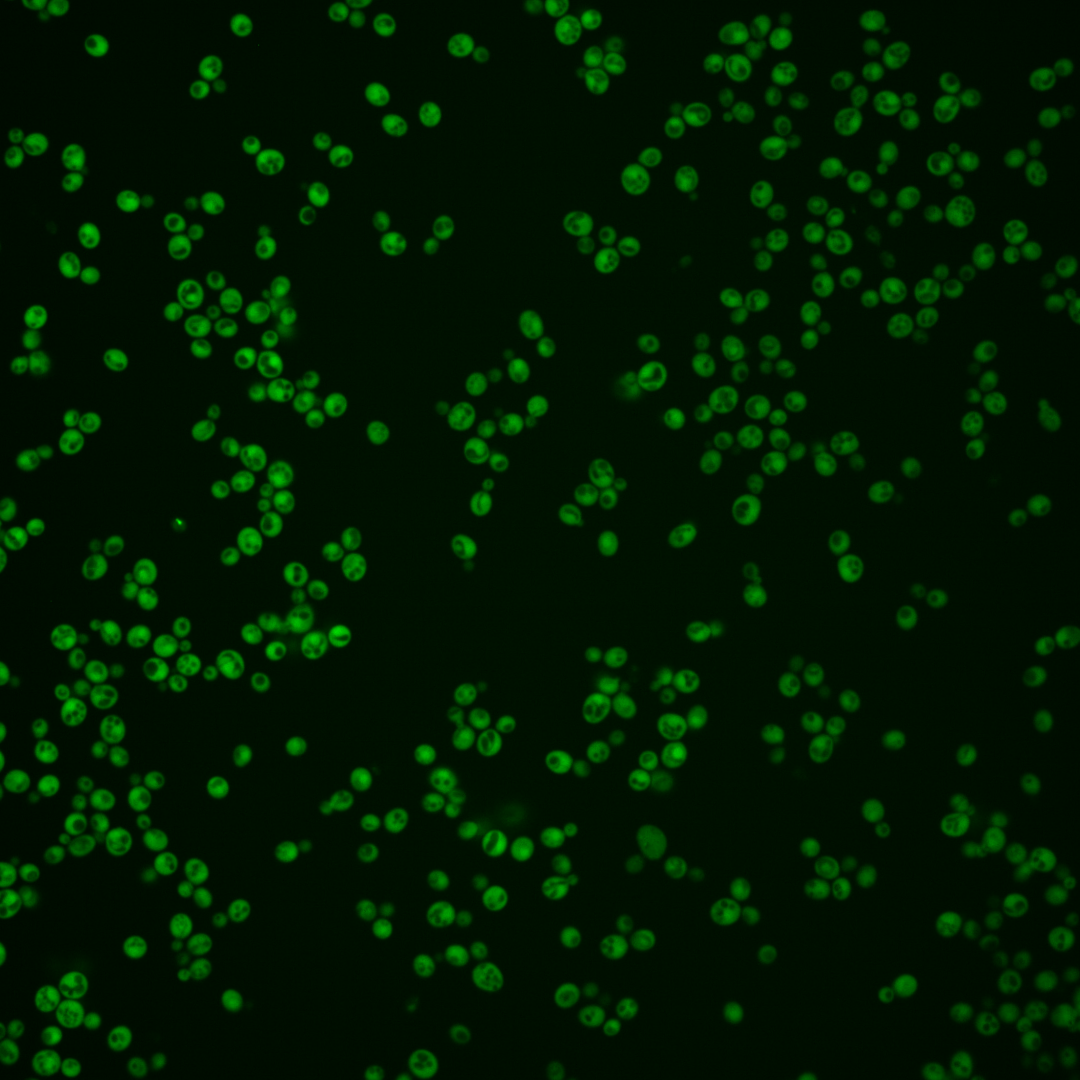

| ORF | |
|---|---|
| Human Ortholog | |
| Description | Phosphatase with a broad substrate specificity; has some similarity to GPM1/YKL152C, a phosphoglycerate mutase; YOR283W is not an essential gene |
Micrographs




















































































Sub-cellular Localization
Yeast GFP Assignment
Protein Abundance
Localization Change
External localization resources
| ensLOC | DeepLoc | |||||||||||||||||||||||
|---|---|---|---|---|---|---|---|---|---|---|---|---|---|---|---|---|---|---|---|---|---|---|---|---|
| Localization | WT1 | WT2 | WT3 | RAP60 | RAP140 | RAP220 | RAP300 | RAP380 | RAP460 | RAP540 | RAP620 | RAP700 | HU80 | HU120 | HU160 | rpd3Δ_1 | rpd3Δ_2 | rpd3Δ_3 | WT1 | WT2 | WT3 | AF100 | AF140 | AF180 |
| Cortical Patches | 0 | 0 | 0 | 0 | 0 | 1 | 2 | – | 1 | 1 | 9 | 5 | 0 | 0 | 0 | 0 | 0 | 0 | 2 | 0 | 0 | 0 | 0 | 0 |
| Bud | 0 | 0 | 0 | 0 | 1 | 1 | 0 | – | 0 | 0 | 3 | 0 | 0 | 0 | 0 | 0 | 0 | 0 | 1 | 0 | 0 | 0 | 2 | 2 |
| Bud Neck | 0 | 0 | 0 | 0 | 0 | 0 | 0 | – | 0 | 0 | 0 | 0 | 0 | 0 | 0 | 0 | 0 | 0 | 0 | 0 | 0 | 0 | 0 | 0 |
| Bud Site | 0 | 0 | 0 | 0 | 0 | 0 | 0 | – | 0 | 0 | 0 | 0 | 0 | 0 | 0 | 0 | 0 | 0 | – | – | – | – | – | – |
| Cell Periphery | 1 | 0 | 1 | 1 | 2 | 1 | 3 | – | 4 | 9 | 4 | 3 | 2 | 1 | 1 | 1 | 1 | 1 | 0 | 0 | 0 | 0 | 0 | 0 |
| Cytoplasm | 169 | 235 | 184 | 259 | 293 | 194 | 337 | – | 212 | 245 | 253 | 215 | 193 | 315 | 377 | 49 | 74 | 66 | 176 | 219 | 183 | 161 | 267 | 213 |
| Endoplasmic Reticulum | 1 | 1 | 1 | 6 | 10 | 3 | 16 | – | 10 | 13 | 17 | 15 | 2 | 2 | 2 | 2 | 0 | 2 | 0 | 0 | 0 | 1 | 3 | 5 |
| Endosome | 0 | 0 | 0 | 0 | 0 | 0 | 0 | – | 0 | 0 | 2 | 2 | 0 | 0 | 0 | 0 | 0 | 0 | 0 | 1 | 0 | 0 | 0 | 0 |
| Golgi | 1 | 1 | 0 | 0 | 0 | 1 | 0 | – | 1 | 5 | 2 | 4 | 0 | 0 | 1 | 0 | 0 | 0 | 0 | 0 | 0 | 0 | 1 | 0 |
| Mitochondria | 1 | 0 | 0 | 0 | 0 | 3 | 2 | – | 17 | 7 | 19 | 33 | 0 | 0 | 0 | 0 | 1 | 0 | 0 | 1 | 0 | 1 | 0 | 0 |
| Nucleus | 4 | 1 | 3 | 5 | 6 | 0 | 22 | – | 17 | 13 | 19 | 21 | 0 | 0 | 1 | 2 | 0 | 0 | 3 | 6 | 2 | 1 | 2 | 6 |
| Nuclear Periphery | 0 | 0 | 0 | 0 | 0 | 0 | 0 | – | 0 | 0 | 0 | 1 | 0 | 0 | 0 | 0 | 0 | 0 | 0 | 0 | 0 | 0 | 0 | 0 |
| Nucleolus | 0 | 0 | 0 | 0 | 0 | 0 | 0 | – | 0 | 1 | 0 | 0 | 0 | 0 | 0 | 1 | 0 | 0 | 0 | 0 | 0 | 0 | 0 | 0 |
| Peroxisomes | 0 | 0 | 0 | 0 | 0 | 0 | 0 | – | 0 | 0 | 0 | 0 | 0 | 0 | 0 | 0 | 0 | 0 | 0 | 0 | 0 | 0 | 0 | 0 |
| SpindlePole | 0 | 0 | 0 | 0 | 0 | 0 | 0 | – | 0 | 0 | 0 | 0 | 0 | 0 | 0 | 0 | 0 | 0 | 0 | 0 | 0 | 0 | 0 | 0 |
| Vac/Vac Membrane | 6 | 0 | 2 | 14 | 32 | 25 | 106 | – | 60 | 104 | 83 | 130 | 0 | 0 | 1 | 5 | 4 | 2 | 2 | 2 | 1 | 1 | 1 | 5 |
| Unique Cell Count | 178 | 237 | 188 | 272 | 328 | 226 | 450 | 306 | 372 | 387 | 403 | 194 | 316 | 380 | 55 | 77 | 68 | 192 | 235 | 189 | 170 | 283 | 238 | |
| Labelled Cell Count | 183 | 238 | 191 | 285 | 344 | 229 | 488 | 322 | 398 | 411 | 429 | 197 | 318 | 383 | 60 | 80 | 71 | 192 | 235 | 189 | 170 | 283 | 238 | |
Yeast GFP Assignment
Protein Abundance
| Screen | WT1 | WT2 | WT3 | RAP60 | RAP140 | RAP220 | RAP300 | RAP380 | RAP460 | RAP540 | RAP620 | RAP700 | HU80 | HU120 | HU160 | rpd3Δ_1 | rpd3Δ_2 | rpd3Δ_3 | AF100 | AF140 | AF180 |
|---|---|---|---|---|---|---|---|---|---|---|---|---|---|---|---|---|---|---|---|---|---|
| Mean Cell GFP Intensity (1e-4) | 22.5 | 23.6 | 20.7 | 21.3 | 21.3 | 13.5 | 15.2 | – | 12.1 | 11.8 | 11.5 | 11.1 | 24.5 | 24.7 | 23.9 | 22.3 | 23.9 | 23.9 | 24.2 | 23.5 | 23.9 |
| Std Deviation (1e-4) | 6.6 | 4.5 | 3.3 | 3.5 | 4.1 | 3.3 | 2.7 | – | 2.1 | 2.0 | 2.0 | 1.9 | 4.4 | 4.3 | 4.1 | 5.8 | 6.3 | 6.0 | 6.3 | 5.4 | 5.6 |
| Intensity Change (Log2) | – | – | – | 0.04 | 0.04 | -0.62 | -0.45 | – | -0.77 | -0.81 | -0.85 | -0.9 | 0.24 | 0.26 | 0.2 | 0.11 | 0.21 | 0.2 | 0.22 | 0.18 | 0.21 |
Localization Change
| Localization | RAP60 | RAP140 | RAP220 | RAP300 | RAP380 | RAP460 | RAP540 | RAP620 | RAP700 | HU80 | HU120 | HU160 | rpd3Δ_1 | rpd3Δ_2 | rpd3Δ_3 |
|---|---|---|---|---|---|---|---|---|---|---|---|---|---|---|---|
| Cortical Patches | 0 | 0 | 0 | 0 | – | 0 | 0 | 0 | 0 | 0 | 0 | 0 | 0 | 0 | 0 |
| Bud | 0 | 0 | 0 | 0 | – | 0 | 0 | 0 | 0 | 0 | 0 | 0 | 0 | 0 | 0 |
| Bud Neck | 0 | 0 | 0 | 0 | – | 0 | 0 | 0 | 0 | 0 | 0 | 0 | 0 | 0 | 0 |
| Bud Site | 0 | 0 | 0 | 0 | – | 0 | 0 | 0 | 0 | 0 | 0 | 0 | 0 | 0 | 0 |
| Cell Periphery | 0 | 0 | 0 | 0 | – | 0 | 0 | 0 | 0 | 0 | 0 | 0 | 0 | 0 | 0 |
| Cytoplasm | -1.5 | -3.5 | -4.3 | -6.8 | – | -7.7 | -8.5 | -8.6 | -10.8 | 1.4 | 2.0 | 1.4 | -2.9 | -0.8 | -0.4 |
| Endoplasmic Reticulum | 0 | 0 | 0 | 2.2 | – | 0 | 0 | 2.5 | 2.2 | 0 | 0 | 0 | 0 | 0 | 0 |
| Endosome | 0 | 0 | 0 | 0 | – | 0 | 0 | 0 | 0 | 0 | 0 | 0 | 0 | 0 | 0 |
| Golgi | 0 | 0 | 0 | 0 | – | 0 | 0 | 0 | 0 | 0 | 0 | 0 | 0 | 0 | 0 |
| Mitochondria | 0 | 0 | 0 | 0 | – | 3.3 | 0 | 3.1 | 4.0 | 0 | 0 | 0 | 0 | 0 | 0 |
| Nucleus | 0 | 0 | 0 | 2.0 | – | 2.2 | 1.3 | 1.9 | 2.1 | 0 | 0 | 0 | 0 | 0 | 0 |
| Nuclear Periphery | 0 | 0 | 0 | 0 | – | 0 | 0 | 0 | 0 | 0 | 0 | 0 | 0 | 0 | 0 |
| Nucleolus | 0 | 0 | 0 | 0 | – | 0 | 0 | 0 | 0 | 0 | 0 | 0 | 0 | 0 | 0 |
| Peroxisomes | 0 | 0 | 0 | 0 | – | 0 | 0 | 0 | 0 | 0 | 0 | 0 | 0 | 0 | 0 |
| SpindlePole | 0 | 0 | 0 | 0 | – | 0 | 0 | 0 | 0 | 0 | 0 | 0 | 0 | 0 | 0 |
| Vacuole | 2.3 | 3.8 | 4.1 | 6.9 | – | 6.0 | 7.7 | 6.5 | 8.5 | 0 | 0 | 0 | 0 | 0 | 0 |
External localization resources
Images






























Protein Concentration and Protein Localization Data
| R1 | R2 | R3 | ||||||||||||||||
|---|---|---|---|---|---|---|---|---|---|---|---|---|---|---|---|---|---|---|
| G1 Pre-START | G1 Post-START | S/G2 | Metaphase | Anaphase | Telophase | G1 Pre-START | G1 Post-START | S/G2 | Metaphase | Anaphase | Telophase | G1 Pre-START | G1 Post-START | S/G2 | Metaphase | Anaphase | Telophase | |
| Concentration | 11.1492 | 13.6615 | 12.4695 | 11.2676 | 9.7552 | 12.034 | 17.1288 | 21.6199 | 19.6091 | 18.9843 | 17.1285 | 20.4837 | 18.5035 | 23.1701 | 20.5692 | 20.6269 | 19.3347 | 20.0835 |
| Actin | 0.0068 | 0.0003 | 0.0002 | 0.0821 | 0.0135 | 0.0001 | 0.0009 | 0.0001 | 0.0078 | 0.0109 | 0.0247 | 0.0001 | 0.0002 | 0.0001 | 0.0002 | 0.0001 | 0.0001 | 0.0003 |
| Bud | 0.0002 | 0.0003 | 0.0001 | 0.0001 | 0.0011 | 0.0001 | 0.0001 | 0.0001 | 0.0003 | 0.0005 | 0.0005 | 0.0001 | 0.0001 | 0.0001 | 0 | 0 | 0.0001 | 0.0001 |
| Bud Neck | 0.0008 | 0.0001 | 0.0002 | 0.005 | 0.001 | 0.0008 | 0.0002 | 0.0001 | 0.0003 | 0.0019 | 0.0046 | 0.0006 | 0.0002 | 0.0001 | 0.0002 | 0.0002 | 0.0003 | 0.0006 |
| Bud Periphery | 0.0002 | 0.0001 | 0 | 0.0001 | 0.0021 | 0 | 0.0001 | 0 | 0.0002 | 0.0005 | 0.0006 | 0 | 0 | 0 | 0 | 0 | 0 | 0 |
| Bud Site | 0.0009 | 0.0001 | 0.0001 | 0.0001 | 0.001 | 0 | 0.0002 | 0 | 0.0017 | 0.0002 | 0.0017 | 0 | 0.0001 | 0.0001 | 0 | 0 | 0 | 0 |
| Cell Periphery | 0.0001 | 0 | 0 | 0.0001 | 0.0001 | 0 | 0 | 0 | 0 | 0.0001 | 0.0001 | 0 | 0 | 0 | 0 | 0 | 0 | 0 |
| Cytoplasm | 0.8948 | 0.981 | 0.9588 | 0.8442 | 0.8288 | 0.9254 | 0.9118 | 0.9865 | 0.937 | 0.9552 | 0.8947 | 0.963 | 0.9482 | 0.9897 | 0.9672 | 0.977 | 0.941 | 0.9357 |
| Cytoplasmic Foci | 0.0071 | 0.0005 | 0.0014 | 0.0008 | 0.0235 | 0.0016 | 0.0167 | 0.0004 | 0.0105 | 0.0009 | 0.0055 | 0.0003 | 0.002 | 0.0002 | 0.0005 | 0.0003 | 0.0006 | 0.0006 |
| Eisosomes | 0.0001 | 0 | 0 | 0.0002 | 0.0001 | 0 | 0 | 0 | 0 | 0 | 0.0001 | 0 | 0 | 0 | 0 | 0 | 0 | 0 |
| Endoplasmic Reticulum | 0.0026 | 0.0009 | 0.0015 | 0.003 | 0.0026 | 0.0023 | 0.0017 | 0.0003 | 0.0012 | 0.0052 | 0.0018 | 0.0005 | 0.001 | 0.0001 | 0.0004 | 0.0001 | 0.0005 | 0.0007 |
| Endosome | 0.0103 | 0.0004 | 0.0027 | 0.0012 | 0.0245 | 0.0058 | 0.0192 | 0.0001 | 0.0098 | 0.0019 | 0.0073 | 0.0001 | 0.0002 | 0 | 0.0001 | 0.0001 | 0.0002 | 0.0002 |
| Golgi | 0.0022 | 0.0001 | 0.0001 | 0.0014 | 0.0139 | 0.0001 | 0.0035 | 0 | 0.0049 | 0.0007 | 0.0129 | 0 | 0 | 0 | 0 | 0 | 0 | 0 |
| Lipid Particles | 0.01 | 0 | 0.0002 | 0.0002 | 0.0095 | 0 | 0.0041 | 0 | 0.0048 | 0 | 0.001 | 0 | 0.0002 | 0 | 0 | 0 | 0 | 0 |
| Mitochondria | 0.0031 | 0.001 | 0.0001 | 0.0002 | 0.0241 | 0.0002 | 0.0011 | 0 | 0.005 | 0.0006 | 0.003 | 0.0001 | 0.0001 | 0.0001 | 0.0001 | 0 | 0.0001 | 0.0002 |
| None | 0.0027 | 0.0004 | 0.0007 | 0.0004 | 0.0043 | 0.0005 | 0.0013 | 0.0005 | 0.0017 | 0.0003 | 0.0004 | 0.0003 | 0.001 | 0.0003 | 0.0004 | 0.0002 | 0.0005 | 0.0004 |
| Nuclear Periphery | 0.0068 | 0.0019 | 0.0043 | 0.0047 | 0.0056 | 0.0059 | 0.0131 | 0.0007 | 0.0017 | 0.0016 | 0.0115 | 0.0022 | 0.0044 | 0.0005 | 0.002 | 0.0009 | 0.0034 | 0.0028 |
| Nucleolus | 0.0009 | 0 | 0 | 0 | 0.0002 | 0 | 0.0002 | 0 | 0.0001 | 0 | 0.0002 | 0 | 0 | 0 | 0 | 0 | 0 | 0 |
| Nucleus | 0.0419 | 0.0123 | 0.028 | 0.0547 | 0.0246 | 0.0537 | 0.0195 | 0.011 | 0.008 | 0.0188 | 0.0201 | 0.0323 | 0.0345 | 0.0086 | 0.0284 | 0.0209 | 0.052 | 0.0576 |
| Peroxisomes | 0.0029 | 0 | 0 | 0.0002 | 0.0115 | 0 | 0.002 | 0 | 0.0025 | 0 | 0.002 | 0 | 0 | 0 | 0 | 0 | 0 | 0 |
| Punctate Nuclear | 0.0027 | 0.0002 | 0.0005 | 0.0007 | 0.0036 | 0.0006 | 0.0026 | 0.0001 | 0.0016 | 0.0001 | 0.0052 | 0.0002 | 0.0073 | 0.0001 | 0.0002 | 0.0001 | 0.0009 | 0.0004 |
| Vacuole | 0.0021 | 0.0004 | 0.0008 | 0.0003 | 0.0025 | 0.0023 | 0.0008 | 0.0001 | 0.0005 | 0.0004 | 0.0015 | 0.0002 | 0.0002 | 0 | 0.0001 | 0.0001 | 0.0002 | 0.0002 |
| Vacuole Periphery | 0.0006 | 0.0001 | 0.0003 | 0.0001 | 0.0019 | 0.0004 | 0.0011 | 0 | 0.0004 | 0.0001 | 0.0005 | 0 | 0.0001 | 0 | 0 | 0 | 0.0001 | 0.0001 |
Sequencing Data
| R1 | R2 | |||||||||
|---|---|---|---|---|---|---|---|---|---|---|
| G1 Post-START | S/G2 | Metaphase | Anaphase | Telophase | G1 Post-START | S/G2 | Metaphase | Anaphase | Telophase | |
| Gene Expression | 45.3781 | 37.0069 | 32.7416 | 36.2623 | 33.03 | 35.0093 | 34.5394 | 26.2257 | 29.4073 | 41.3092 |
| Translational Efficiency | 2.3674 | 2.5558 | 2.3293 | 1.8631 | 2.4466 | 2.3786 | 2.2444 | 2.3009 | 2.2131 | 2.2265 |
Hit Data
| Dataset | Hit |
|---|---|
| Protein Concentration | ✘ |
| Protein Localization | ✘ |
| Gene Expression | ✘ |
| Translational Efficiency | ✘ |
Endocytosis
| Temp | Actin Patch (Sac6-tdTomato) | Cortical Patch (Sla1-GFP) | Late Endosome (Snf7-GFP) | Vacuole (Vph1-GFP) |
|---|---|---|---|---|
| 37℃ | ||||
| RT |
Cell Cycle Omics
CYCLoPs (Yor283w-GFP)
| Gene / Allele | Actin Patch (Sac6-tdTomato) | Cortical Patch (Sla1-GFP) | Late Endosome (Snf7-GFP) | Vacuole (Sac6-tdTomato) |
|---|
| Gene | Images |
|---|
| Gene | Images |
|---|
Images are not yet available
Images are not yet available